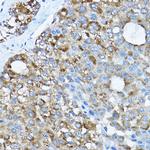
RPL36 Antibody in Immunohistochemistry (Paraffin) (IHC (P))

Search
Invitrogen
RPL36 Polyclonal Antibody
{{$productOrderCtrl.translations['antibody.pdp.commerceCard.promotion.promotions']}}
{{$productOrderCtrl.translations['antibody.pdp.commerceCard.promotion.viewpromo']}}
{{$productOrderCtrl.translations['antibody.pdp.commerceCard.promotion.promocode']}}: {{promo.promoCode}} {{promo.promoTitle}} {{promo.promoDescription}}. {{$productOrderCtrl.translations['antibody.pdp.commerceCard.promotion.learnmore']}}

Please note: We are reviewing Western blot images included in the antibody testing data in our catalog, including those provided by third parties. Unless expressly labeled or annotated as “raw-unedited”, Western blot images included in the antibody testing data in our catalog may have been edited, optimized or otherwise adjusted for presentation.
产品信息
PA5-117106
种属反应
宿主/亚型
分类
类型
抗原
偶联物
形式
浓度
规格
纯化类型
保存液
内含物
保存条件
运输条件
RRID
产品详细信息
Positive Samples: PC-12, HepG2, Jurkat, HeLa, Mouse spleen, Mouse lung, Rat spleen, Rat lung
靶标信息
The exosome is involved in a multitude of cellular RNA processing and degradation events. DIS3, also known as exosome complex exonuclease RRP44, is a ribonuclease that acts directly in the processing, turnover, and surveillance of a large number of distinct RNA species. DIS3 localizes to both the cytoplasm and the nucleus and contains one PINc domain. It is widely expressed with highest expression in testis and is required for processing of 7S pre-RNA into a mature nuclear complex and, ultimately, for proper mitotic progression. Abnormal expression levels of DIS3 may be associated with colon cancer, suggesting a role for DIS3 in tumorigenesis.
仅用于科研。不用于诊断过程。未经明确授权不得转售。
篇参考文献 (0)
生物信息学
蛋白别名: 60S ribosomal protein L36; Large ribosomal subunit protein eL36
基因别名: RPL36
UniProt ID: (Rat) P39032, (Mouse) P47964
Entrez Gene ID: (Rat) 58927, (Mouse) 54217



